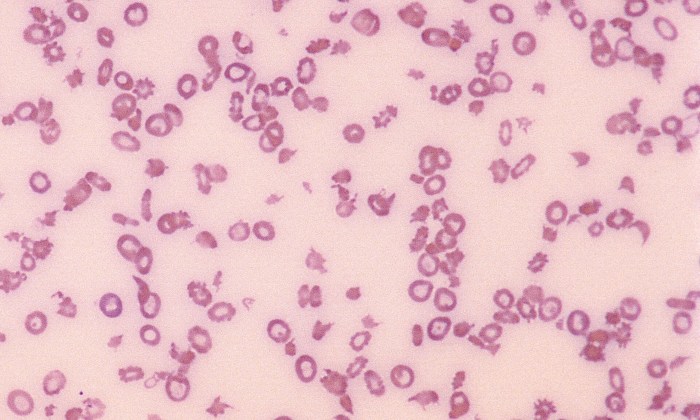
Poikilocytosis 5 (Canine 1 - Splenic Mass)

Poikilocytosis

Morphology: poikilocyte is a generic term to describe red blood cells with abnormal shape. Poikilocytosis refers to large numbers of abnormally shaped red blood cells.
Commonly seen with: poikilocytosis may include acanthocytes, echinocytes, eccentrocytes, keratocytes, and schizocytes as well as red blood cells with abnormal shape that do not fit available descriptors. Poikilocytosis may be accompanied by features of various underlying disorders.
Clinical relevance: depends on number, shape, and context. Marked poikilocytosis may be normal in young ruminants, some goat breeds, and pigs with artifactual crenation of erythrocytes. Pathological poikilocytosis is common in sick cats (ie. liver disease, cardiomyopathy, etc) and in animals receiving chemotherapy.